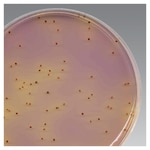

Search
- Home
- Shop All Products
- Additional Dehydrated Culture Media Supplements

Oxoid™ 万古霉素添加剂
Thermo Scientific™ Oxoid 万古霉素添加剂可添加至选择性培养基,用于从临床标本中分离万古霉素耐药性肠球菌 (Vancomycin Resistant Enterococci, VRE) 和高水平氨基糖苷类耐药性肠球菌 (High Level Aminoglycoside Resistant Enterococci, HLARE)。